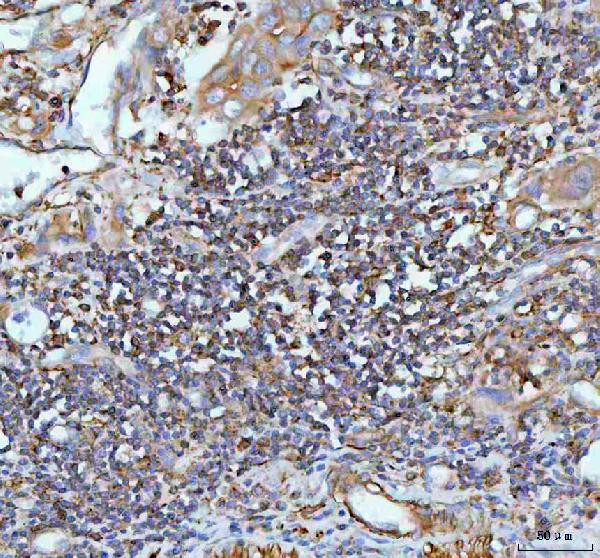
IL-22 Antibody in Immunohistochemistry (Paraffin) (IHC (P))

Search
Invitrogen
IL-22 Polyclonal Antibody
{{$productOrderCtrl.translations['antibody.pdp.commerceCard.promotion.promotions']}}
{{$productOrderCtrl.translations['antibody.pdp.commerceCard.promotion.viewpromo']}}
{{$productOrderCtrl.translations['antibody.pdp.commerceCard.promotion.promocode']}}: {{promo.promoCode}} {{promo.promoTitle}} {{promo.promoDescription}}. {{$productOrderCtrl.translations['antibody.pdp.commerceCard.promotion.learnmore']}}
图: 1 / 5
IL-22 Antibody (PA5-95459) in IHC (P)





Please note: We are reviewing Western blot images included in the antibody testing data in our catalog, including those provided by third parties. Unless expressly labeled or annotated as “raw-unedited”, Western blot images included in the antibody testing data in our catalog may have been edited, optimized or otherwise adjusted for presentation.
产品信息
PA5-95459
种属反应
宿主/亚型
分类
类型
抗原
偶联物
形式
浓度
规格
纯化类型
保存液
内含物
保存条件
运输条件
RRID
产品详细信息
Human IL-22 shares 81.4% amino acid (aa) sequence identity with mouse IL-22.
Reconstitute with 0.2 mL of distilled water to yield a concentration of 500 µg/mL.
Positive Control - WB: human placenta tissue, rat thymus tissue, mouse thymus tissue. IHC: human rectum adenocarcinoma tissue, human spleen tissue, mouse thymus tissue.|Store at -20°C for one year from date of receipt. After reconstitution, at 4°C for one month. It can also be aliquotted and stored frozen at -20°C for six months. Avoid repeated freeze-thaw cycles.
靶标信息
IL-22 also known as IL-10-related T-cell derived inducible factor, is an alpha helical cytokine and is considered a member of the IFN-IL-10 family, which includes IL-19, IL-20, IL-24, IL-26, IL-28, IL-29, and the type I and II interferons. IL-22 is produced mainly by activated T cells and NK cells. In humans, the IL-22 gene is located on the q arm of chromosome 12, and is structurally related to IL10. IL-22 acts by engaging the heterodimeric receptor complex consisting of primary receptor IL-22R1 and accessory receptor IL-10R2. IL-22R1 also binds IL-20 and IL-24; IL-10R2 also binds IL-10, IL-27, IL-28, and IL-29. Binding of IL-22 to its receptor complex induces signal transduction, particularly via the JAK-STAT pathway. In addition to the membrane-bound IL-22R1/IL-10R2 complex, a soluble single-chain IL-22 receptor termed IL-22BP has been found to antagonize IL-22 binding and signaling. IL-22 appears not to directly influence immune cells, and major targets of the cytokine appear to be nonimmune cells, such as cells of the skin, digestive and respiratory system, as well as hepatocytes, and keratinocytes. IL-22 has been described as an effector cytokine of the Th17 lineage. Along with IL-17A and IL-17F, IL-22 regulates genes associated with innate immunity of the skin. IL-17A, IL-17F and IL-22 are all co-expressed by Th17 cells, however, they are differentially regulated. The effects of IL-22 include induction of acute phase reactants and antimicrobial proteins, as well as increasing the mobility of keratinocytes. IL-22 is highly expressed during chronic inflammation, and found to activate intracellular kinases and transcription factors. IL-22 is critical for host defense against infections of extracellular pathogens, and promotes wound-healing responses. IL-22 is upregulated in activated T cells. IL-22 has been reported to mediate IL-23-induced acanthosis and dermal inflammation through activation of STAT3.
仅用于科研。不用于诊断过程。未经明确授权不得转售。
篇参考文献 (0)
生物信息学
蛋白别名: il 22; IL-10-related T-cell-derived-inducible factor; IL-22; IL-22a; IL-TIF; IL-TIF alpha; ILN; ILTIF alpha; Interleukin; interleukin 10-related T cell-derived inducible factor; Interleukin-22; Interleukin-22a; Interleukin22
基因别名: IL-22; IL-22a; Il22; Il22a; Iltif; ILTIFa; RGD1561292
UniProt ID: (Mouse) Q9JJY9
Entrez Gene ID: (Mouse) 50929, (Rat) 500836